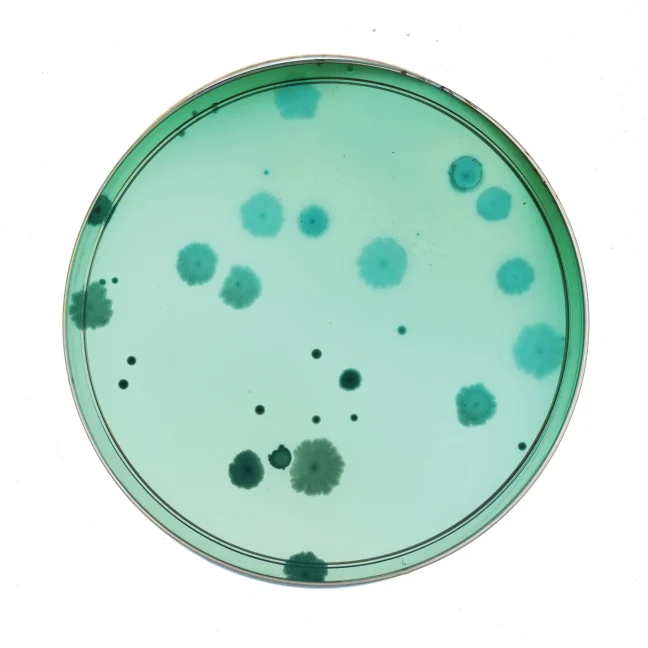

Lactobacillus crispatus.
Day-to-day life can disrupt the balance of your vaginal microbiome, depleting its critical super defender
VS-01TMVaginal Synbiotic
VS-01™ emerged from the discovery that specific strains of L. crispatus defend the vaginal microbiome from pH disruptions and imbalances.

VS-01™ is the first and only vaginal synbiotic clinically validated
- ProbioticEcology
Three proprietary liveL. crispatusprobiotic strains selected for their genomic diversity and strengthening of vaginal stability and resilience: LUCA103™, LUCA011™, LUCA009™.
- PrebioticComplex
Nutrients and molecules that create the ideal environment and energy source for the probiotic strains to not only survive, but thrive.
- SMART TabletrmDelivery
Slow-release delivery technology engineered to maximize exposure to the vaginal wall. Clinically validated as the most effective and superior delivery system, when compared to vaginal and oral formats.

Address the Source, Not the Symptoms
Finally, a sustainable approach to address the root cause of imbalances and sustainably defend against daily disruptions.
2 Month Starter Kit
Month 1 Reset
Your first-month reset to rapidly establish an optimal vaginal microbiome.
Month 2+ Sustain
The two-tablet monthly protocol that maintains stability and protects against pH disruptors.
A New Standard of Safety

Tested For
Tested For
- Biocompatibility with the vaginal environment
- 14 classes of allergens, including gluten, nuts, and soy
- 500+ contaminants (chemical residues and heavy metals)
- Osmolality (typically only tested for in lubricants)
Non-Toxic + Non-lrritating
Non-Toxic + Non-lrritating
- Non-disruptive to the vaginal mucosal barrier in a cruelty-free, FDA-recognized tissue model
- No histological changes or cellular tissue damage
- No adverse toxicity outcomes in gold-standard human clinical trial
From Leading Providers
Questions? We're here to guide you.

What is your 30 day risk-free guarantee? Do you accept returns?
What is your 30 day risk-free guarantee? Do you accept returns?
If for any reason you are not satisfied with your purchase, you may request a refund within 30 days of delivery of your first order. We’ll refund you for the full cost of the product less shipping, VAT, and duties—no questions asked. Refunds apply to your first order only, not any subsequent shipments. For all subsequent shipments, you may reschedule or cancel at any time inyour Account.
What does VS-01™m do?
What does VS-01™m do?
While most available solutions target only the symptoms in ways that further disturb the vagina, VS-01™ addresses the source—the vaginal microbiome. VS-01™ begins with an intensive first month Reset to rapidly establish an optimal vaginal microbiome and continues with monthly Sustain — the simple, two-tablet monthly protocol to maintain a stable vaginal microbiome and regulate pH.
In a double-blind, randomized, placebo-controlled clinical trial, VS-01™ restored and maintained an optimal vaginal microbiome 10x more effectively than a leading oral vaginal probiotic, and 100% of participants experienced regulated vaginal pH.
How long should l take VS-01m for?
How long should l take VS-01m for?
VS-01™ is designed for ongoing use to rapidly establish and then maintain a resilient vaginal microbiome less prone to disruptions from day-to-day life. VS-01™ is also rigorously third-party evaluated and verified safe for long-term use.
Who should take VS-01?
Who should take VS-01?
VS-01™ is recommended for adults ages 18-55.
Kindly note, your body’s natural lubrication is required for optimal dissolution of VS-01™. As such, VS-01™ may not be as effective among individuals experiencing significant vaginal dryness.If you experience significant vaginal dryness, please consult your physician.
Is VS-01m safe?
Is VS-01m safe?
VS-01™ has a rigorous safety profile through clinical (in humans) and preclinical (in laboratory environments) testing. VS-01™ is extensively third-party evaluated for contaminants, heavy metals, impurities and all classes of allergens. It is formulated with gentle, non-irritating ingredients and tested for safety and vaginal biocompatibility using an FDA-recognized tissue model.
Can l use VS-01t while menstruating?
Can l use VS-01t while menstruating?
It is recommended that you do not use VS-01™ while experiencing moderate to heavy bleeding, in order to allow the VS-01™ vaginal tablet to fully dissolve in the vagina and maximize absorption. Day 1 of each protocol starts as soon as bleeding stops.
Note that it is completely fine to insert VS-01™ while spotting or experiencing light bleeding.
If you experience breakthrough bleeding, <28 day cycles, or irregular periods that may disrupt the VS-01™ protocol, do not worry. Take each tablet as close to the schedule as possible.
Start Sustain Day 1 five to seven days after your Reset is complete.
You can always modify your next VS-01™ shipment in your account dashboard or by reaching out to our care team—care@seed.com.
How do l use my HSA/FSA to pay?
How do l use my HSA/FSA to pay?
You can place an order online using your FSA or HSA card (as you would any other credit or debit card). We’ve taken all of the necessary steps on our end to ensure that you can use your FSA or HSA funds to purchase VS-01™. We also recommend consulting your provider to determine what documentation is required to have your claim approved, as many providers require a Letter of Medical Necessity (LMN) in addition to a receipt.
What does my subscription to VS-01mm Vaginal Synbiotic include?
What does my subscription to VS-01mm Vaginal Synbiotic include?
Your first shipment of VS-01™ Vaginal Synbiotic contains a 2 month Starter Kit. You’ll start your first month with a Reset protocol of six VS-01™ vaginal synbiotic tablets to seed an optimal vaginal microbiome and regulate pH. After that, you’ll continue your second month with a Sustain protocol of two vaginal tablets to maintain a stable vaginal microbiome and protect against pH disruptors.
After your first shipment, your subscription provides a monthly supply of the VS-01™ Sustain protocol. Returning VS-01™ subscribers can enroll in our Sustainable Refill Program to receive 3-month refills at a discount.
How do l use VS-01™?
How do l use VS-01™?
Menstruation is one of the most known day-to-day disruptors of the vaginal microbiome. VS-01™ is designed to work with your body’s unique cycle by rapidly restoring your vaginal microbiome with an initial Reset, and then maintaining stability and regulated pH with monthly use.
Gently press a VS-01™ vaginal tablet out of the aluminum pack into washed hands before each use. Place the VS-01™ vaginal tablet securely into an applicator. Insert into your vagina, and push the inner tube towards you to release (just like a tampon). After releasing, remove and dispose of the applicator. Please note that each applicator is a Class I Medical Device and cannot be recycled.
Can l be sexually active while using VS-01m?
Can l be sexually active while using VS-01m?
Yes—you can be sexually active while using VS-01™, though we recommend abstaining from sexual activity for 12 hours after inserting a tablet, to allow the tablet enough time to dissolve completely.